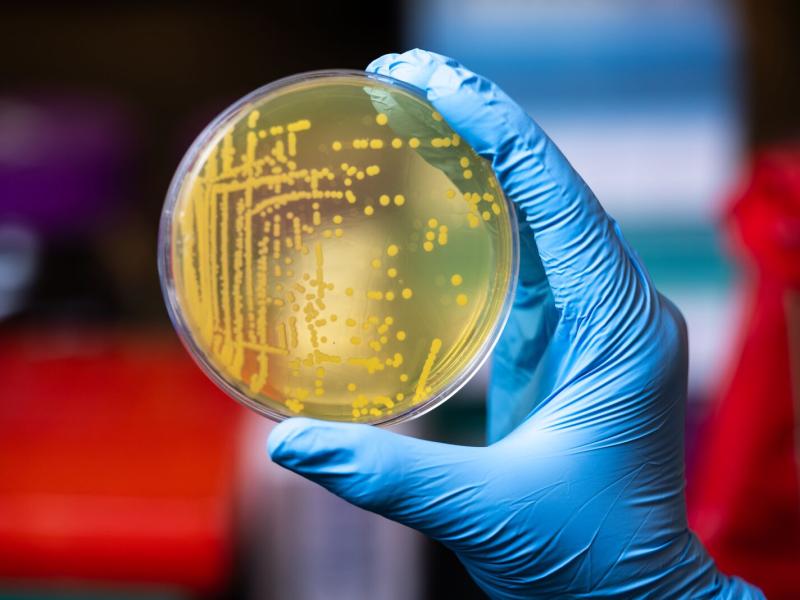
Photograph of a bacterial plate sample being held by a researcher

Featured Stories
March 16, 2026
PNNL Brings Open-Source GPU Acceleration to Quantum with NVIDIA NVQLink
March 16, 2026
Protein Design Principles Revealed in AI Analysis of Nanoribbon Assembly
March 10, 2026
Autonomy Accelerates Science on a National Scale
March 5, 2026
PNNL Strengthens U.S. Supply of Key Feedstock for Quantum Technologies
Subscribe
to receive PNNL
news by email:
Latest Stories
603 results found
Filters applied: Ecosystem Science, Biology